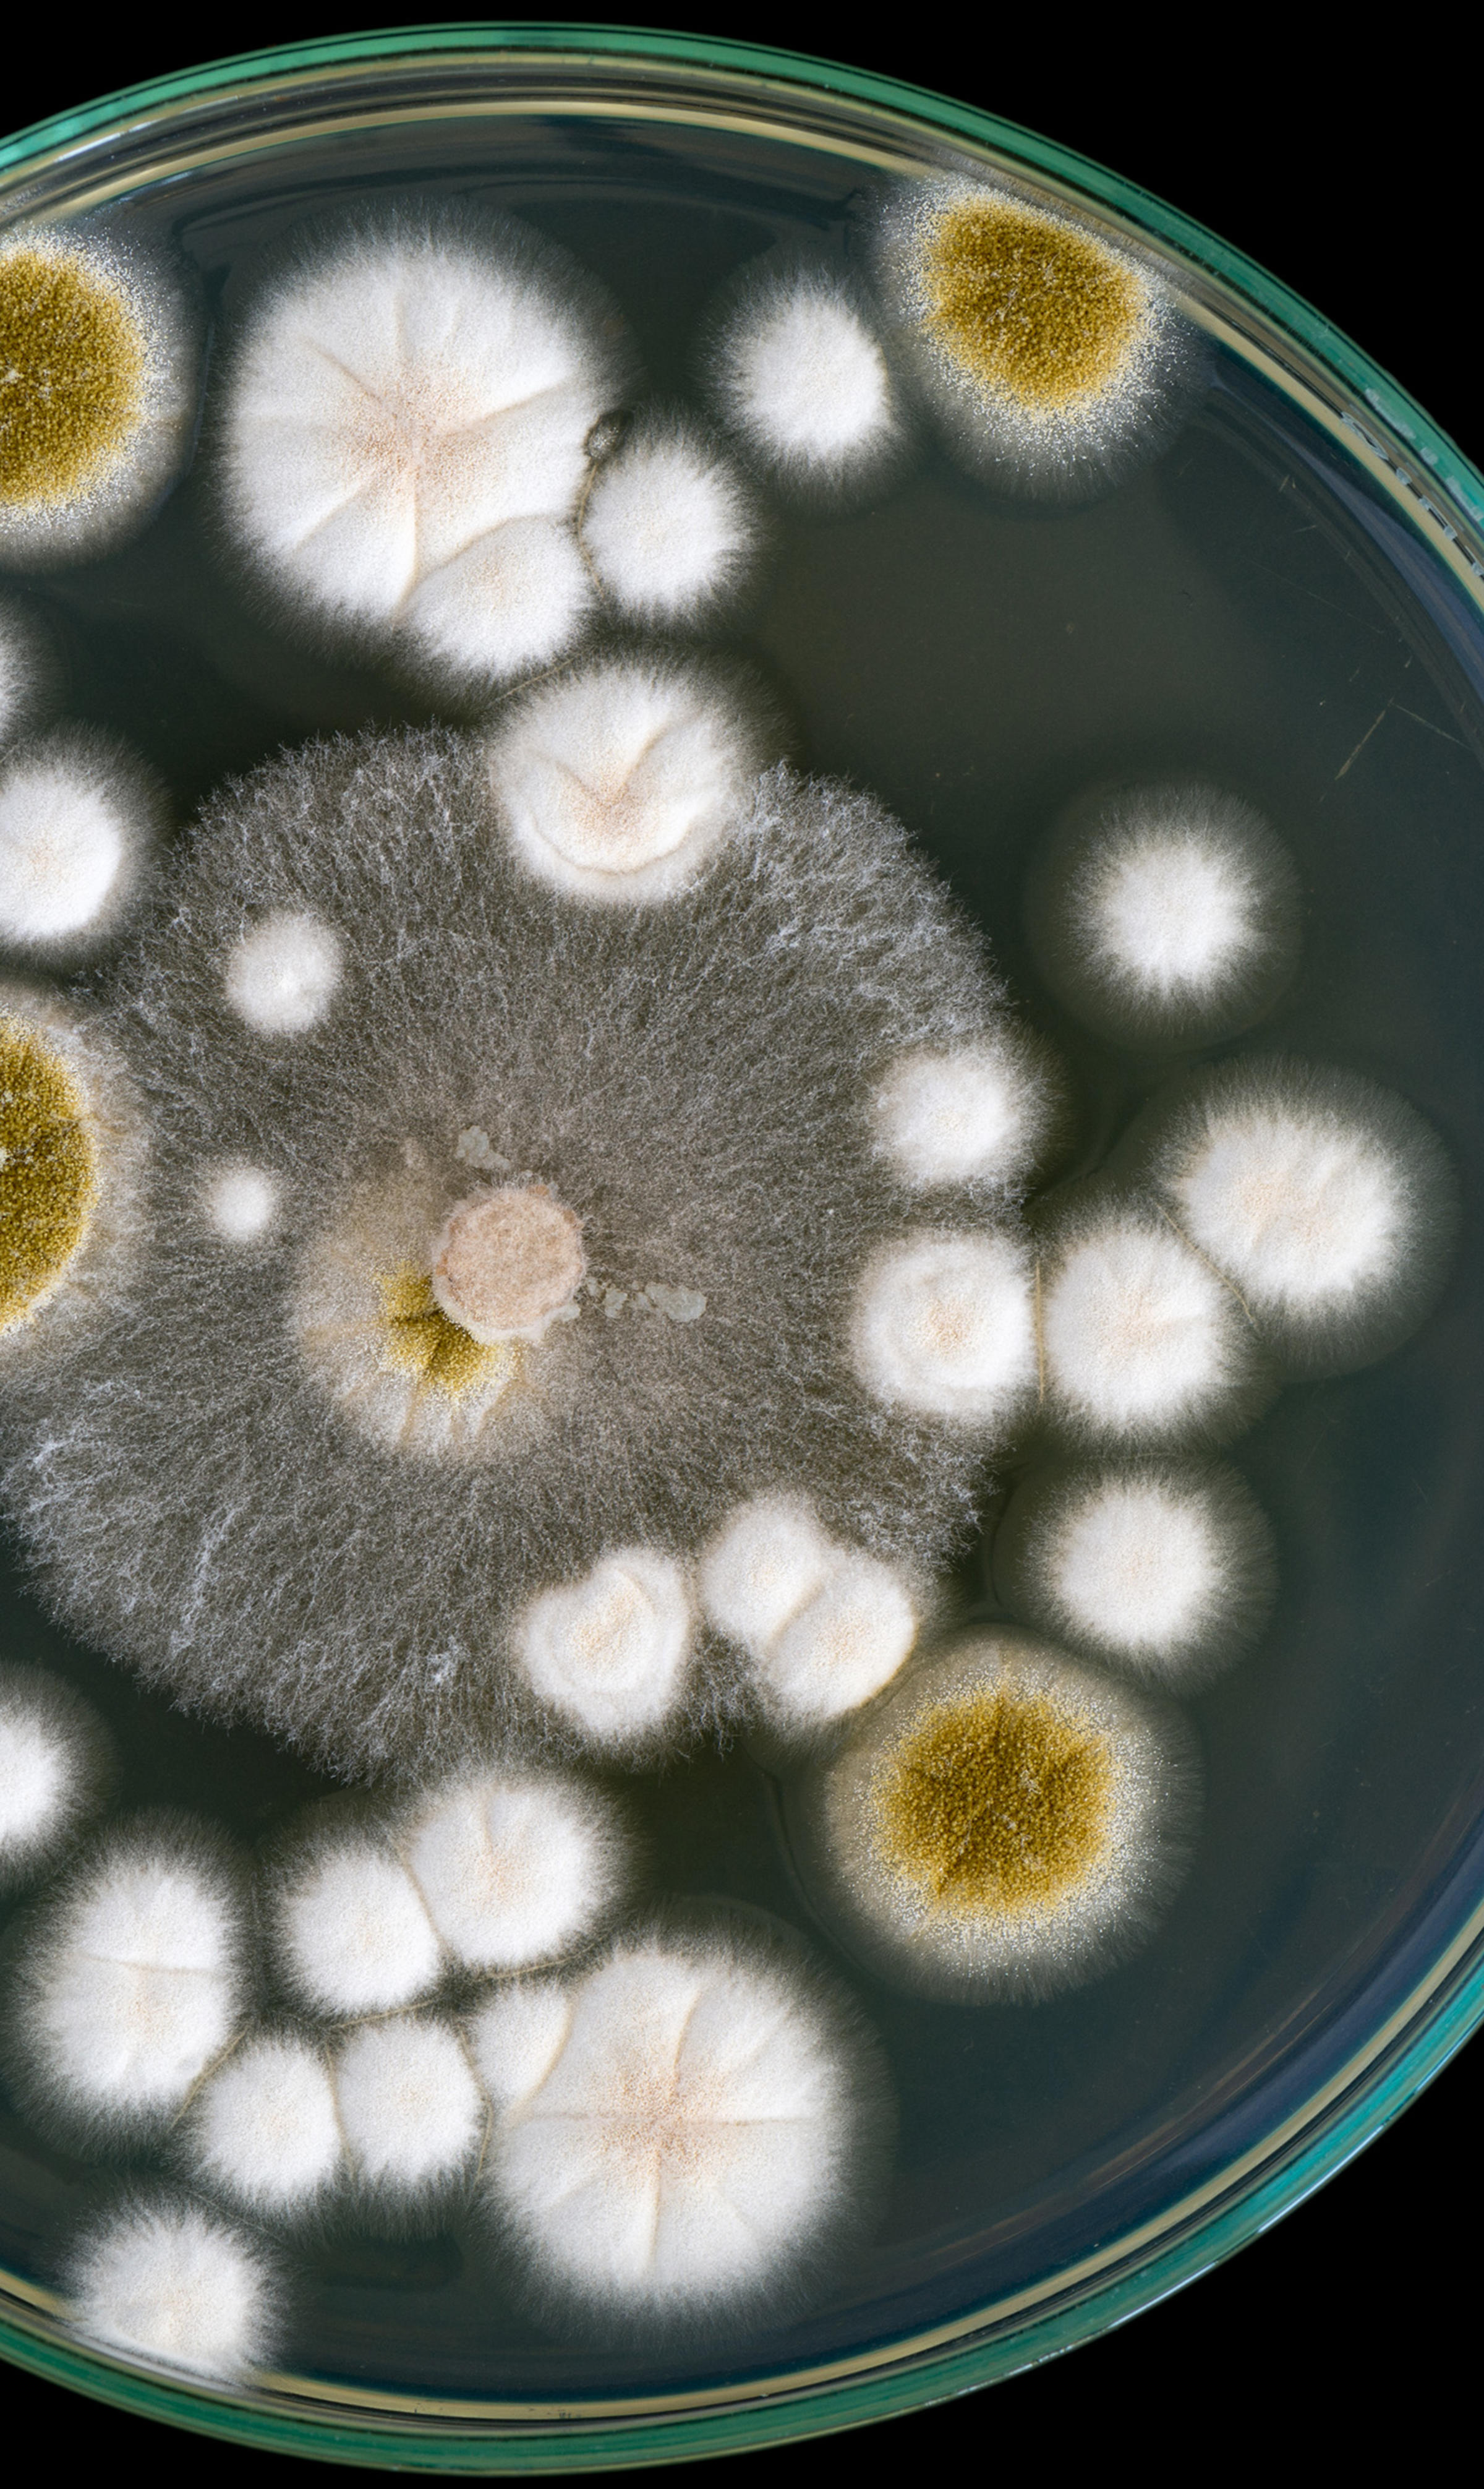
Mold spores on a petri dish

The Deeper Story
Theresa MacPhail is an associate professor in Stevens’ Science and Technology program. She is also a medical anthropologist — a profession with particular relevance in a moment when the COVID-19 global pandemic has created a heightened sensitivity about both our health and modern medicine.
Anthropology is grounded in detailed observation of particular groups in extended proximity — a process known as “embedding.” Medical anthropologists spend lots of time in offices and labs and hospitals, listening to what doctors, researchers and public health officials say and watching them at work over time.
“The method is observing people,” MacPhail says. “Interacting with them. And hanging out long enough that you stop believing everything that they say.... What anthropology tries to get at is: ‘What are people saying about what they’re doing?’ And then looking at their actual behaviors and trying to parse out: ‘How does all of that work?’”
MacPhail’s new book, Allergic: Our Irritated Bodies in a Changing World (Random House), widens this frame of observation in the culture of allergy and examines an even broader network: patients, community advocates, and even the marketers who flood our airwaves with ads for their latest pharmaceutical product. Readers meet not only doctors and researchers chasing the science of allergy, but patients just like themselves, seeking diagnoses and cures, as well as parents of seriously ill children wrestling with moral conundrums and guilt.
“I want to talk to as many people as I possibly can,” says MacPhail. “Because eventually, I’m going to see patterns. I’m going to get the larger story.” Allergic demonstrates how her approach can offer deeper insight into a common health issue with a life-changing — and even fatal — potential for causing medical mayhem.
The book fizzes with a dizzying array of new information about how the ways in which we sneeze, itch, break out in hives and rashes (and even sicken seriously and die) have intensified over recent decades. The most startling revelation in MacPhail’s research is a growing body of evidence that our immune systems are overburdened by the rapid pace of changes — internal and external — that include climate change, diet, and even when and how we first encounter allergens.
When it comes to allergies, humanity has already met the enemy: ourselves. “Everything we’ve been doing for the last 200 years ... is irritating us — slowly, imperceptibly, constantly,” she writes.
Coping With the Specter of Death
The questions to which MacPhail gravitates — allergies, pandemics, aging — are among the most vexing in contemporary medicine. Her quest for answers often begins by reflecting on her own personal narrative, including tragic events. Her brother perished in an accident when she was only four yours old, and her mother died in a car accident a decade later.
“Unfortunately for me, I have kind of an unusual background, where I was introduced to death repeatedly and young,” MacPhail recalls. “So, I’ve always been fascinated by how people cope with the specter of death and the specter of illness.”
Personal narratives are baked into her anthropological pursuit, which acknowledges (and accounts for) the presence of the researcher within the process. Allergic begins with MacPhail relating another tragic occurrence: the sudden death of her father in 1996 from a fatal reaction to a single bee sting.
“When you’re researching something like influenza, or even allergies, you’re on the dark side of things,” she says. “I’ve always been on the dark side of things. And I’m curious about them. So, I want the answers to them. That’s probably selfish, because part of me just wants the answers for me.”
MacPhail graduated from the University of New Hampshire in 1994 with a joint degree in English and journalism. After a few years working in media, she embarked on a different course, leading from a master’s program at New York University to a joint Ph.D. from the University of California, Berkeley, and University of California, San Francisco.
“When I was doing the Ph.D.,” she recalls, “I remember during my oral exams, one of my professors asked me what’s the difference between long-form journalism and ethnography. And I said, in fact, they’re not that different.”
There are divergences, to be sure. “I am not trying to be objective as a medical anthropologist, because I know I can’t be,” says MacPhail. “And I’m asking different questions.... The way [journalists] go about asking questions is different.”
Yet there are strong parallels. “People who do long-form journalism have covered the same beat for 20 years. That’s really close to what an anthropologist does,” she observes.
“I feel like I’m still a journalist,” says MacPhail. “Just a journalist plus.”
“Everything we’ve been doing for the last 200 years ... is irritating us — slowly, imperceptibly, constantly.” — Theresa MacPhail
The Flu Bug
MacPhail’s first book, The Viral Network: A Pathography of the H1N1 Influenza Pandemic (Cornell, 2014), was rooted in close anthropological observation. Living in Hong Kong for a few years in the early 2000s — and immersion in that city’s unique and pervasive relationship with influenza — led her to take up the discipline.
“I started getting really, really interested in how normal people thought about something like flu, or sickness or what it meant to be healthy,” MacPhail recalls. “So I decided to pursue it, and get a Ph.D. in medical anthropology, because I was told: These are the questions that anthropology tries to answer.”
Her opportunity to embed at the U.S. Centers for Disease Control and Prevention (CDC) in the fall of 2009 and witness how the U.S. formulated its response to the 2009–2010 H1N1 influenza pandemic is central to The Viral Network. It is a book that grapples with how researchers and policymakers acquire and disseminate reliable information to confirm and track pandemics — as well as develop counter-measures.
MacPhail’s firsthand experiences also inform her observations about the difficulties that public health officials have faced in coping with COVID-19 a decade later. “It’s not if, but when, something is going to get us,” she says. “And these people are aware of that. They are just trying to get us ready, but nobody wants that information.”
Our Allergies, Our Stories
Allergic marshals a broad array of facts and statistics about the increasing discomfort we feel from our allergies. (Did you know half of Uganda’s population has a sensitization to at least one allergen?) MacPhail also lays out the problems (and opportunities) in how we test and treat the irritations and malfunctions that cluster largely in our diets, on our skin and in our respiratory systems. (The U.S. alone spent $6.7 billion on allergy drugs in 2020.)
MacPhail’s stylistic clarity ensures that Allergic’s comprehensive approach never slips into mere compendium. And her methodology offers readers detailed interviews with leading allergy researchers and experts that sum up the limits of present science and historical context. She also asks hard questions about the interplay between public demands for relief and the pharmaceutical industry’s readiness to supply it — with all the immense risks and costs that come with it.
Readers also emerge with a new understanding of two central propositions about allergy.
The first is rather surprising: The workings of the human immune system largely remain a mystery to medicine. Dr. Paulina Guerrerio — a prominent food allergy researcher and clinician at the National Institutes of Health — tells MacPhail bluntly: “We still don’t understand the mechanisms behind immune tolerance, to be honest, or why we tolerate some things, but not others.”
The second proposition is the growing evidence that radical changes in our own environment have disrupted our immune systems more than ever in human history.
MacPhail writes that the artificial foundations of our consumer culture — food, clothing, shampoos, plastics — have raced so far ahead of our capacity to absorb these innovations that “our immune systems could clearly use a break.” And climate change’s broad impacts on weather patterns have created a perfect breeding ground for allergens such as pollen, mold and ragweed.
“There isn’t a single area within the United States,” she writes, “that isn’t seeing the direct effects of climate change on allergens.”
These propositions are underpinned by indelible portraits of parents, patients and others on the front lines that are drawn from her immersion in the culture of allergy.
Anna Kelly, a monitoring and analysis supervisor at the Southwest Ohio Air Quality Agency, takes MacPhail up on the roof to examine the devices that measure the pollen and air pollution that drive many of us to swallow Allegra and Benadryl for an increasing part of the year. MacPhail also introduces readers to Emily Brown, a Missouri mother whose child’s extensive food and skin allergy plunged her family into poverty. Brown’s response was to create a nonprofit — The Food Equity Initiative — to help families obtain food from an allergy-friendly and gluten-free food pantry.
“It’s just never forgetting that these stories are about people,” says MacPhail. “This is not about allergy, it’s about people with allergies, and what it’s doing to all of us.”
To balance Allergic’s sheer intensity, MacPhail offers strategic pauses within the text to offer frank assessments (and reassurance) about the practical questions that her research raises about diet, testing, treatment — and even feelings of parental guilt.
“I was constantly looking at points where I felt overwhelmed, and I felt that someone else is definitely going to feel overwhelmed,” says MacPhail. “It’s my responsibility to get people through that material safely — and with an understanding of the world that can maybe help them in some way.”
Allergic is grounded in anthropology’s primary question: How does the challenge to our bodies posed by allergies affect the total human being?
“Allergies are the biggest evidence we have that the way in which we’re changing our environment is harmful to us.” — Theresa MacPhail
“People just want to pick up a book and go: ‘Well, what’s the solution to allergy?’” she observes. “And from the very beginning with my editor, I said: ‘Listen, that’s not this book. I’m not going to sell people on a false sense of security. I want people to understand ... that allergies are the biggest evidence we have that the way in which we’re changing our environment is harmful to us.”
Expanding the Conversation
MacPhail is now turning her attention to society’s tangled responses to aging.
“I just turned 51,” she says. “And I want to know: What’s going to happen to me? Or what potentially is going to happen to me?”
Yet larger questions also press to the front: “Why are we spending $6 billion on aging, and only $6 million on hay fever? It’s because we’re all terrified of aging... So, I’m going all the way back. I’m trying to figure out at what point did aging become an illness. It used to just be a normal thing, right? It’s just a part of life. And now, if you look at the science and the science writing around aging, it’s: ‘Here’s how to stop aging.’”
MacPhail says Stevens cultivates an environment that encourages scholars to seek out broader audiences. “A lot of people doing good work are only talking to 12 other people,” she says. “I think we really need to get better about training people like me to write for general audiences as well … Stevens is really on the cutting edge with that.”
The stakes of broadening the audience for the essential information that scholars glean from academic research are high. “We can’t just be having a conversation amongst ourselves,” MacPhail observes. “We have to be letting the public know why what we do matters.”
— Richard Byrne